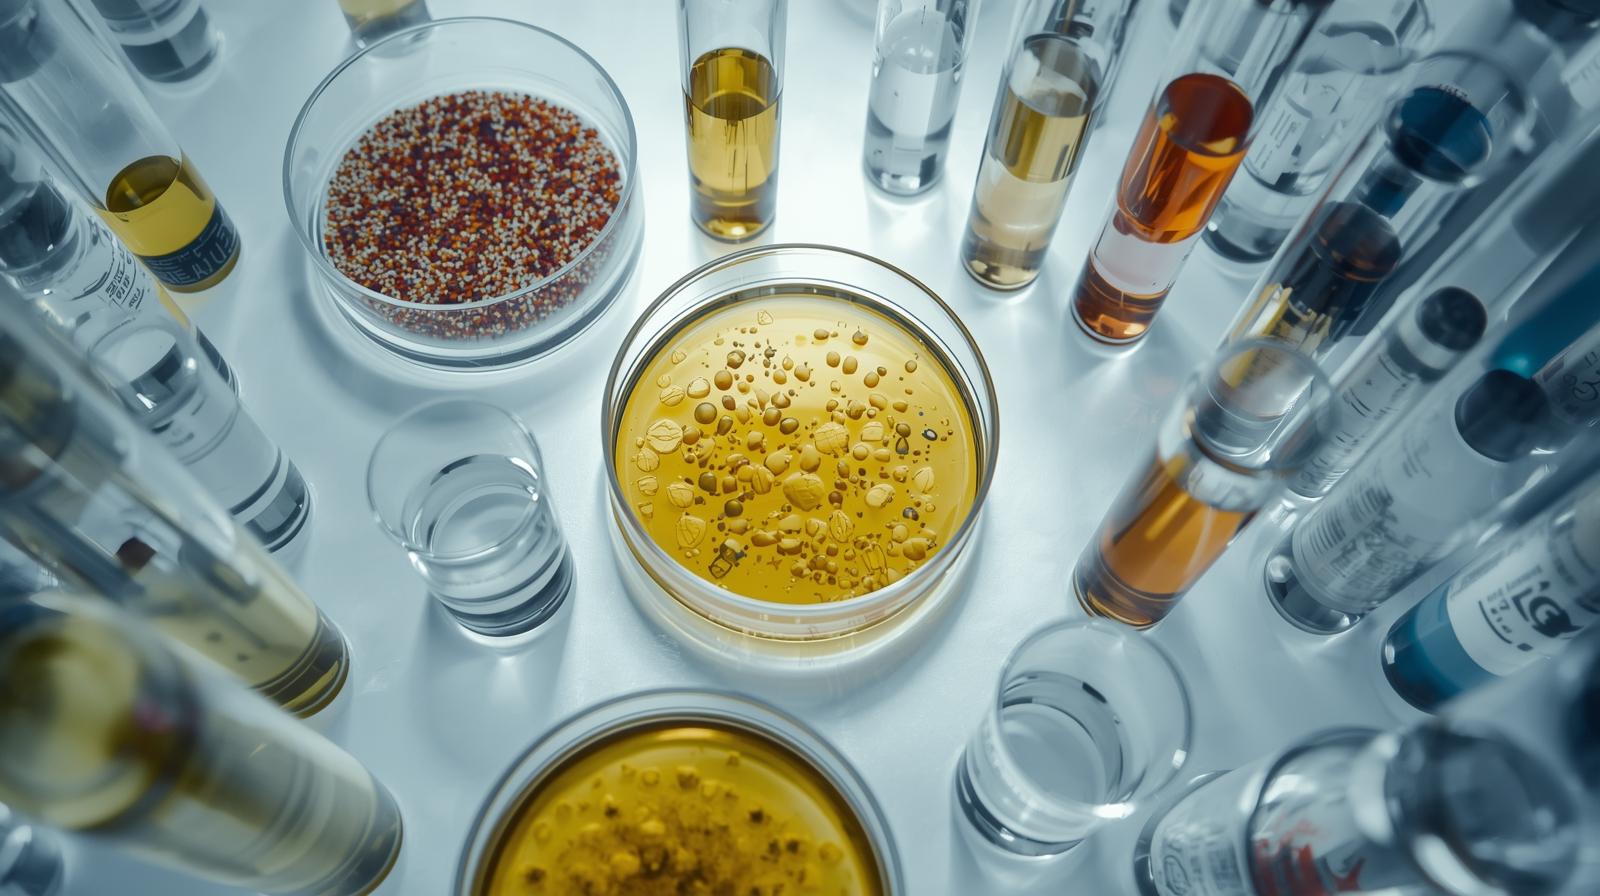

Allgemeines

Weihnachtsspeck ade – Wie nehme ich am Bauch am schnellsten ab?
Die Kerzen fangen zu brennen an, das Kühlschranktor ist aufgetan… und das Festtagsbäuchla wächst. Glühwein, Plätzchen, Weihnachtsfeier hier, Freund*innen treffen da und zack sind 2, 3 nicht wirklic...
Weiterlesen
Protein-Power – Welche Funktionen hat Eiweiß im Körper?
Proteine sind seit geraumer Zeit in aller Munde. Vor allem bei Sportbegeisterten lancieren High Protein-Produkte weit oben, denn Eiweiß ist nötig für ein gesundes Muskelwachstum. Dort hört der Wirk...
Weiterlesen
Bad fat oder doch O-mega!? Die besten Quellen sowie Tipps für ein gesundes Fettsäureverhältnis.
Fett in unseren Speisen hatte sehr lange einen eher mäßigen Ruf: zu viel davon ist schlecht fürs Cholesterin, fürs Gewicht, für die Gefäße usw. Dadurch wurden Low Fat-Diäten immer populärer – ebens...
Weiterlesen
Clean Eating – dein Einstiegsguide
Unverarbeitete Lebensmittel, oder auch Clean Eating genannt, sind aktuell einer DER Trends, wenn es um gesunde Ernährung und Lebensweisen geht. Aber dass dieser “Trend” seine Wurzel in der vegetari...
Weiterlesen
Protein Overload – ist zu viel Eiweiß ungesund?
Eiweiß spielt eine wichtige Rolle, wenn es um grundlegende Funktionen unseres Körpers geht. Doch wie viel Eiweiß ist genau richtig, wie viel ist zu viel und welche Gefahren birgt übermäßiger Protei...
Weiterlesen
Plantbased Meal Prep – Der ultimative Guide für deine Woche 🍽️
Meal Prep ist eine Begrifflichkeit, welche sich in der letzten Zeit eine stetig wachsende Bühne geschaffen hat. Immer öfter sieht man die geneigte Kollegin im Büro weniger in der Warteschlange der ...
WeiterlesenWie viel Protein am Tag brauchen wir?
Proteine, auch als Eiweiße bekannt, sind essentielle Makroährstoffe, zusammen mit Fetten und Kohlenhydraten, die für zahlreiche Funktionen in unserem Körper unverzichtbar sind. In diesem Artikel er...
Weiterlesen
Wie nehme ich am schnellsten ab?
🍏 Das Wichtigste in Kürze Schnell und gesund abnehmen: Schnell und gleichzeitig gesund ist relativ. Langanhaltende und gesunde Gewichtsverluste lassen sich nicht von heute auf morgen bewirken. ...
Weiterlesen
Bedingt essentielle und nicht essentielle Aminosäuren
Aminosäuren sind die Bausteine der Proteine – und diese sind wiederum essentiell für zahlreiche Vorgänge in unserem Körper (Zellaufbau, Enzyme, Hormone, Immunsystem und vieles mehr). Der menschlich...
Weiterlesen
Quick and yummy: Schnelle vegane Protein-Rezepte
💡 Das Wichtigste in Kürze Schnelle Zubereitung: Alle Rezepte sind in maximal 30 Minuten fertig (ohne Garzeit) Proteinreich & vegan: Perfekt für Muskelaufbau, Sättigung, gesunde Ernährung...
Weiterlesen
Essentielle Aminosäuren vegan – Alles, was du wissen musst
Die drei Grundbausteine unserer Ernährung sind die sogenannten Makronährstoffe: Kohlenhydrate, Fette und Proteine – sozusagen die heilige Dreifaltigkeit der Nahrungsmittel. Sie sind nicht nur für d...
Weiterlesen
Gesund plantbased abnehmen – ohne Jo-Jo-Effekt
"Abnehmen" – ein Begriff, der oft mit Verzicht, Selbstkasteiung und Stress in Verbindung gebracht wird. Dass das Ganze aber auch ohne Entsagung und den gefürchteten Jo-Jo-Effekt geht, zeigen wir di...
Weiterlesen
Protein‑Check: Fit mit pflanzlichem Eiweiß
Aktuell lauert ein wahres Bombardement an "High Protein"-Produkten in den Ladengeschäften auf dich: Brot, Shakes oder Aufstriche. Dass solche Nahrungsmittel nicht nur überteuert sondern auch gar n...
Weiterlesen
Flexi‑Vegan: Teilzeit tierfrei zum Abnehmen
Vegan = schmerzhafter Verzicht? Eine Prämisse, mit der rein pflanzliche Ernährung immer noch zu kämpfen hat. Aber warum straight edge wenn der Weg zu einer gesunden, bewussten Lebensweise mit klein...
Weiterlesen
Biologische Wertigkeit einfach erklärt
Wenn du dich mit Ernährung und vor allem Sport und Ernährung beschäftigst, bist du gewiss schon mal über den Begriff Biologische Wertigkeit (BW) von Proteinen gestolpert. Aber was genau soll das e...
Weiterlesen
🥗Low‑Fat vs. Low‑Carb – Welche pflanzenbasierte Diät ist effektiver zum Abnehmen?
Wir schauen uns gemeinsam diese beiden etablierten Diät-Formen an und geben dir einen Einblick in deren Vor- und Nachteile. Eine kleine Ratgeberin. 🔥 Das Wichtigste in Kürze Kurzfristiger Vor...
Weiterlesen
So errechnest du deinen Kalorienbedarf
Das Wichtigste in Kürze 🔢 Individueller Kalorienbedarf: Dein täglicher Kalorienverbrauch hängt von Alter, Gewicht, Geschlecht und Aktivität ab. 🔥 Kalorienverbrauch berechnen: Mit einem Kalorienr...
Weiterlesen
Tipps um deinen Stoffwechsel anzuregen
🔥 Das Wichtigste in Kürze ⚡ Stoffwechsel-Booster: Bestimmte Lebensmittel und Bewegungsformen können den Stoffwechsel effektiv anregen. 🥗 Ernährung als Schlüssel: Proteinhaltige Mahlzeiten mit Cr...
Weiterlesen
Diese Nahrungsergänzungsmittel/Supplements brauchst du als Veganer
🌱 Das Wichtigste in Kürze 🔬 Essenzielle Nährstoffe: Bei einer veganen Ernährung sollten Vitamin B12, Eisen, Omega-3 und Proteine im Fokus stehen. 🍽 Optimale Versorgung: Durch ausgewogene Mahlzei...
Weiterlesen
So bekämpfst du effektiv Heißhunger
✨ Das Wichtigste in Kürze 🍔 Heißhunger verstehen: Meist durch Blutzuckerschwankungen, Stress oder Nährstoffmangel ausgelöst. 🌟 Die richtige Ernährung hilft: Proteinreiche Mahlzeiten mit Creative...
Weiterlesen